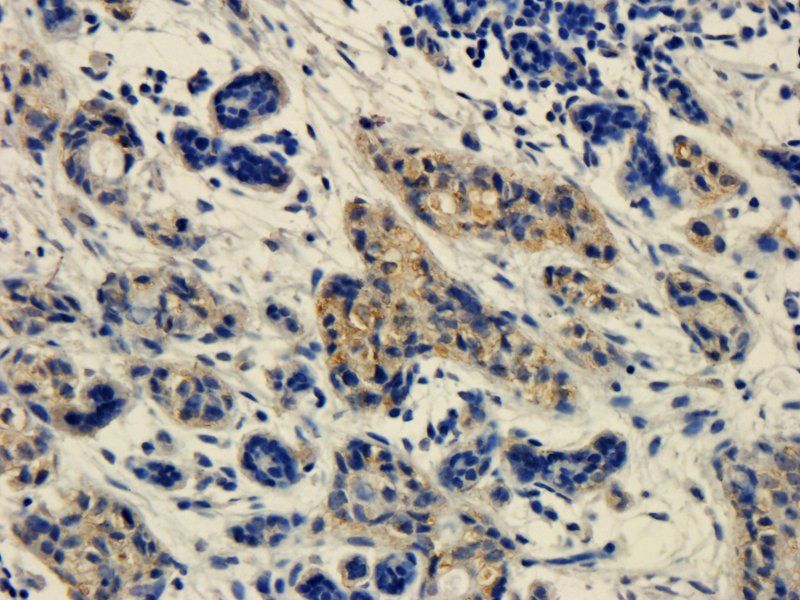
SEMA3A antibody

You have no items in your shopping cart.
- NDUFA9 Antibody [orb1972535]
ELISA, FC, ICC, IF, IHC, WB
Human, Mouse, Rat
Rabbit
Polyclonal
Unconjugated
100 μg - CD274 antibody [orb10162]Featured

ELISA, IHC-P, WB
Human, Mouse, Rat
Rabbit
Polyclonal
Unconjugated
100 μg, 200 μg - ATAD2 Antibody [orb31113]Featured

ELISA, ICC, IF, IHC-P
Human, Mouse, Porcine, Rat
Rabbit
Polyclonal
Unconjugated
100 μg - IGF1 antibody [orb10886]Featured

ELISA, ICC, IF, IHC-P, WB
Bovine, Canine, Human, Mouse, Porcine, Rat, Sheep
Rabbit
Polyclonal
Unconjugated
100 μg - ENO1 Antibody [orb688875]
ELISA, FC, IF, IHC, IP, WB
Human, Mouse, Rabbit, Rat
Mouse
Monoclonal
Unconjugated
50 μl, 100 μl - GLUD1 Rabbit Polyclonal Antibody [orb579551]
IHC, WB
Human, Rat
Bovine, Canine, Equine, Guinea pig, Mouse, Porcine, Rabbit, Sheep, Zebrafish
Rabbit
Polyclonal
Unconjugated
100 μl - SEMA3A antibody [orb11359]Featured

ICC, IF, IHC-P, WB
Human, Mouse, Rat
Rabbit
Polyclonal
Unconjugated
100 μg - Featured

IF, IHC-Fr, IHC-P, WB
Human, Mouse, Rat
Hamster, Insect
Mouse
Monoclonal
Unconjugated
1 ml, 100 μl, 500 μl, 200 μl - IL1 alpha antibody [orb308737]Featured

ELISA, ICC, IF, IHC-P, WB
Human, Mouse, Rat
Rabbit
Polyclonal
Unconjugated
100 μg